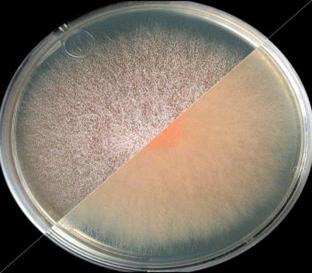

Біосинтез гіберелінів
У країнах Південно-Східної Азії здавна відомо
захворювання рису, назване в Японії бакане. Найхарактернішим його симптомом є
стрімке зростання уражених рослині, які різко виділяються на загальному тлі. Ще
на початку XX століття японські вчені припустили, що причина цього - виділення
грибом Gibberella fujikuroi, збудник захворювання, особливих речовин у тканини
рослин.
В кінці 30-х років ХХ століття було виділено
активну речовину, що викликає такі ж симптоми як і гриби паразити. Цю речовину
назвали гібереліном за назвою гриба.
В другій половині 50-х років відкрито їх
унікальні властивості як гормональних регуляторів росту рослин. Багатостороння
і дуже висока фізіологічна активність гіберелінів, і в першу чергу їх здатність
забезпечувати зацвітання певних груп рослин в не індуктивних умовах, викликала
величезний інтерес до цих мікробних метаболітів. Інтерес до них збільшився ще
більше, коли з'ясувалося, що гібереліни утворюються не тільки фітопатогенним
грибом р. Gibberella , але і вищими рослинами.
В наш час гібереліни застосовуються в
рослинництві для підвищення виходу волокна конопель та льону, для збільшення
розмірів ягід у безнасінних сортів винограду, для підвищення врожайності трав,
стимуляції проростання насіння. Тому є необхідність пошуку оптимальних, більш
дешевих і ефективних способів їх отримання в промислових масштабах.
Гібереліни - група гормонів рослин, які
регулюють ріст і різноманітні процеси розвитку такі як: подовження стебла,
проростання насіння, цвітіння, прояв статі. Являють собою групу близьких за
будовою тетрациклічних карбонових кислот, що відносяться до дитерпенів.
Позначають символом А з цифрою з права знизу -
порядковим номером, який присвоюється кожному новому з'єднанню по мірі
відкриття та ідентифікації. Найбільш поширений і переважно використовується
гіберелін А3 так само відомий як гіберелова кислота (Рис.1). Це
пояснюється тим, що основний промисловий штам гриба Fusarium - moniliforme
синтезує в основному саме цей гіберелін, який є головним компонентом
препаратів, що надходять у продаж [1].

Рис.1. Гіберелова кислота (А3, ГК3)
Розглянемо більш детально гриби роду
Fusarium (так звані фузарії) - продуцентів гібереліну А3.
У багатьох видів цього роду є тільки
конідіальне спороношення і відсутня статева стадія. Конідіальне спороношення у
фузарій надзвичайно різноманітно по морфології і способу утворення конідій.
Гриби цього роду мають два типи конідій - макро- та мікроконідії [2].
Рис.2. Колонія Fusarium moniliforme

Рис.3 Гіфи Fusarium moniliforme

Рис.4. Макроконідії Fusarium solani

Рис.5. Мікроконідії Fu

Рис.6. Хламідоспори Fusarium solani
Мікроконідії (Рис.5) утворюються
зазвичай в повітряному міцелії на простих або складних конідіях, в ланцюжках
або зібрані в головки, а також часто у вигляді скупчень між гіфами міцелію.
Конідії одноклітинні, рідше з одною і ще рідше з 2-3 перегородками, зазвичай
овальні, яйцеподібні, еліпсоподібні, рідше кулясті, грушоподібні.
У деяких випадках утворюються
склероції - тісне скупчення гіф білуватого, жовтуватого, коричневого або
синього кольору. Це спочиваюча стадія. Розвиваються вони найчастіше в тканинах
субстрату або в грунті і служать у цих грибів, як і хламідоспори (Рис.6), для
перезимівлі та перенесення несприятливих умов, сприяючи тим самим збереженню
виду.
Біосинтез гіберелінів
гіберелін гормон синтез культивування
Сукупність численних даних по
метаболізму гіберелінів дозволяє побудувати загальну схему біосинтезу
С19-гіберелінів. Ранні етапи синтезу гіберелінів, включаючи утворення і
подальше перетворення мевалонової кислоти, є загальними для терпенів і можуть
вважатися твердо встановленими [1]. Загальним тетрациклічним попередником всіх
гіберелінів є каурен. Подальший метаболізм здійснюється через стадії
послідовних окислювальних реакцій: каурен - кауренол - кауреналь - кауренова
кислота (Рис.7).

Рис7. Схема біосинтезу гіберелінів
характерна для грибів роду Fusarium: FPP- фруктозадифосфат, GGDP-гераніл-геранілпірофосфат[3].
Культивування грибів р. Fusarium
Вище було написано, що
зацікавленість до гіберелінів з’явилась після встановлення
їх фітогормональної природи, тоді ж і згадали про можливість використання р.
Fusarium, як продуцента гіберелінів.
В наш час фузарії культивують
поверхневим або зануреним способом на рідкому середовищі Чапека або
Ролена-Тома. Максимум утворення біомаси гриба встановлюється паралельно
максимуму накопичення гіберелінів[4].
Метод поверхневого культивування
Як поживне середовище використовують
сусло-агар на якому фузарії ростуть найшвидше, також використовують
картопляно-глюкозний агар та середовище Ролена-Тома. Гарні результати дає
використання ятрофи (р. Jatropha) як субстрата. Використовуючи макуху ятрофи
дослідники отримали вихід 105 мг/г А3 за 4 дня.
Метод зануреного культивування
Цей метод використовують для
промислового культивування фузарій. Культивування проводять в горизонтальних
роторних біореакторах (рис.8) за оптимальних умов[6].

Рис.8. Горизонтальний роторний біореактор.
F. moniliforme культуру засівають у
250 мл середовища Чапека (що складається з (г / л) сахарози, 30, NaNO3, 3;
K2HPO4, 1; MgSO4.7H2O, 0,5; KCl, 0,5 і FeSO4, 0,01, рН 6,0) і інкубували при 30
° С (в деяких джерелах при 26 ° С) протягом 10 днів при 150 оборотів в хвилину
[6]. GA3 вистоюється в надосадову рідину.
Експотенціальний ріст культури
починається з 2 дня, 4 дні триває лог-фаза. Виробництво GA3 починається на 6-й
день та досягає піку на 8-й день при цьому концентрація GA3 близько 5,8 г / л.
На біосинтез GA3 впливають такі
чинники: температура, аерація, склад поживного середовища, рН та інше.
Вплив рН
Рис. Вплив рН на біосинтез GA3
грибами F.
Moniliforme
при зануреному культивуванні при pH
5 (-■-), pH
7 (-▲-) та pH
8 (-X-).
Встановлено, що з розвитком культури
знижується рН середовища приблизно до 2,2-3,5 [4]. При зануреному культивуванні
в середовищі Чапека максимальний вихід GA3 досягається при рН 7.0 [5] по іншим
даним оптимум рН 5.0 [6].
Вплив температури

Рис. Вплив температури на біосинтез GA3 грибами
F. Moniliforme при зануреному культивуванні . Позначення 23℃
(-X-), 25℃ (-♦-), 30℃
(-▲-) та 37℃ (-■-).
Температура один з головних чинників
який треба враховувати при біосинтезі GA3. Ряд дослідів показує, що оптимальна
температура при якій був максимальний вихід (5,8 г/л ) GA3 30℃
[5].
Вплив аерації
Зміна концентрації О2
також впливає на біосинтез гіберелової кислоти. Провели наступний дослід:
помістили культуру F. moniliforme в інкубатор без доступу кисня [6]. У
закритому інкубаторі, концентрація О2 знизилася з початкових 20,9%
до 3% після 3днів, за рахунок мікробного метаболізму, і залишалася постійною на
рівні 3% наступні 7 днів, незважаючи на те, що вентиляційні отвори на верхній
частині інкубатора були наполовину відкриті.
Через 10 днів вміст GA3 становив 1,4
мг/г (маса GA3/маса сухої речовини) , наступні 9 днів інкубатор тримали з
відкритою кришкою. На 19 день концентрація GA3 зросла до 8,2 мг/г.
В іншому досліді повітряний клапан
інкубатора весь час був повністю відкритим, в
результаті
через 18 днів вихід GA3 склав 19,3 мг/г.
Ці дані показують, що достатня
вентиляція інкубатора дуже важлива, особливо в початковий період росту, коли
відбувається швидке поглинання О2.
Вплив вуглеводів

Рис. Влив джерел карбону на біосинтез GA3
грибами F. Moniliforme . Позначення: глюкоза (-♦-), сахароза (-о-),
галактоза (-■-), ксилоза (-▲-) і метанол (-X-).
Для визначення впливу джерел карбону
в сторону більш високих врожаїв GA3 сахароза в поживному середовищі була
замінена на інші вуглеводи в концентрації 20 г/л.
Найкращий результат 15г/л GA3
отриманий за використання глюкози оптимальних умовах[5]. Інші вуглеводи давали
менший вихід, а метанол та оцтова кислота взагалі пригнічували ріст культури.
Висновок
Гриби роду Fusarium одне з основних
джерел отримання гіберелінів - життєво необхідних фітогормонів рослин.
На основі опрацьованих джерел
[3][4][5][6] можна зробити висновок про оптимальні умови біосинтезу
гіберелінів: занурене культивування при рН 7.0, температурі 30℃,
постійний доступ повітря, як джерело карбону ефективно використовувати сахарозу
та глюкозу.
Перелік літератури
[2]
Жизнь растений: в 6-ти томах. - М.: Просвещение. Под редакцией А. Л.
Тахтаджяна, главный редактор чл.-кор. АН СССР, проф. А.А. Федоров. 1974.
[3]
Claudia
Troncosoa, Ximena Gonzáleza, Christiane Bömkeb, Bettina Tudzynskib,
Fan Gongc, Peter Heddenc, M. Cecilia Rojasa. Gibberellin biosynthesis and
gibberellin oxidase activities in Fusarium sacchari,
Fusarium konzum and Fusarium subglutinans strains.- Phytochemistry, Volume 71,
Issues 11-12, August 2010, Pages 1322-1331.
[4]
Билай В.И. Основы общей микологии. - Киев: Вища школа, 1980. - с. 291.
[5] Improved Production of
Gibberellic Acid by Fusarium / Vidhya Rangaswamy// Journal of Microbiology
Research. - 2012. - 2(3): 51-55
moniliforme
[6] Factors affecting gibberellic
acid production by Fusarium moniliforme in solidstate cultivation on
starch/X.-M. Qian, J.C. du Preez and S.G. Kilian// World Jour